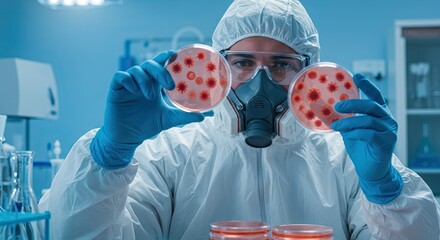
Person in hazmat suit examines petri dishes with cell growths in a bluelit lab

- Home >
- Stock Photos >
- Person in Protective Suit Sanitizing Room with Virus Cells Overlay
Person in Protective Suit Sanitizing Room with Virus Cells Overlay Image

This visual displays a person wearing a protective suit and face mask while disinfecting an area, overlaid with virus cell graphics. It illustrates the themes of hygiene and sanitation during pandemics. This imagery may be used for materials on health safety measures, pandemic awareness campaigns, or educational content about staying safe and clean.
2
downloads
downloads
Tags:
More
Credit Photo
If you would like to credit the Photo, here are some ways you can do so
Text Link
photo Link
<span class="text-link">
<span>
<a target="_blank" href=https://pikwizard.com/photo/person-in-protective-suit-sanitizing-room-with-virus-cells-overlay/2092b705de65ad82723f3fb241f2bd8a/>PikWizard</a>
</span>
</span>
<span class="image-link">
<span
style="margin: 0 0 20px 0; display: inline-block; vertical-align: middle; width: 100%;"
>
<a
target="_blank"
href="https://pikwizard.com/photo/person-in-protective-suit-sanitizing-room-with-virus-cells-overlay/2092b705de65ad82723f3fb241f2bd8a/"
style="text-decoration: none; font-size: 10px; margin: 0;"
>
<img src="https://pikwizard.com/pw/medium/2092b705de65ad82723f3fb241f2bd8a.jpg" style="margin: 0; width: 100%;" alt="" />
<p style="font-size: 12px; margin: 0;">PikWizard</p>
</a>
</span>
</span>
Free (free of charge)
Free for personal and commercial use.
Author: Awesome Content
Similar Free Stock Images
Loading...